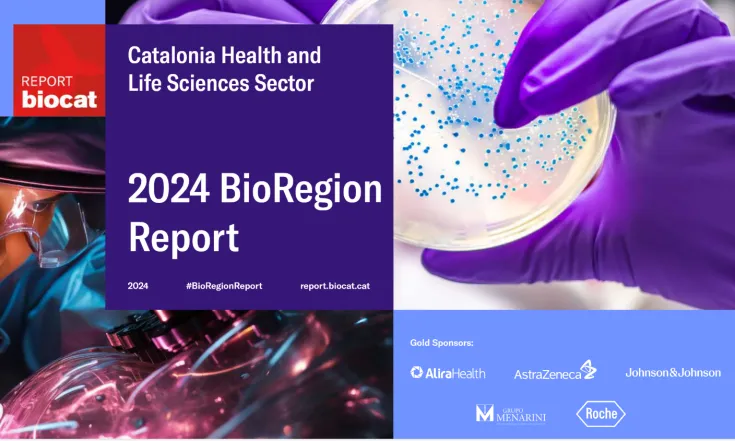
Informe de la BioRegión de Cataluña 2024.

Buscar
Sumario de resultados
TIpos de contenido
Fecha
-

-
Noticia
NoticiaCataluña reafirma su liderazgo en innovación en salud con un nuevo récord de inversión en ...
El sector de las ciencias de la vida y la salud en Cataluña – la BioRegión de Cataluña – se consolida como uno de los principales motores de innovación y desarrollo económico y social del país
-
 Noticia
NoticiaLa genética se convierte en aliada del profesional sanitario
La medicina personalizada ya es una realidad, y la genética, su gran aliada. Para facilitar su aplicación en la práctica clínica, nace N·GENE, una plataforma que traduce el conocimiento genético en
-
 Noticia
NoticiaBCN HEALTH publica un estudio que pone de relieve los elevados costes sanitarios asociados...
BCN HEALTH ha publicado el estudio “Hepatocellular carcinoma: what are the differential costs compared to the general population?” en el Journal of Medical Economics, una revista revisada por pares
-
 Noticia
NoticiaAcelerando el descubrimiento de fármacos mediante una plataforma de diseño in silico
Únete a nuestro evento gratuito el martes 8 de julio en el Parque Científico de Barcelona para una versión extendida de nuestra serie Lunch and Learn donde presentaremos las diversas capacidades de la
-
 Noticia
NoticiaAseBio celebrará su Asamblea General el próximo 11 de junio de 2025
La Asamblea General Ordinaria tendrá lugar tras la presentación del Informe AseBio 2024 de forma presencial en El Beatriz, en Madrid.
-
-
 Empresa
EmpresaCOLFEED4PRINT
-
 Noticia
NoticiaNatac gana el premio ‘Empresa Extremeña’ del Grupo Ros
El galardón reconoce la trayectoria, innovación y contribución de la compañía al desarrollo económico y social de Extremadura
-
 Evento
EventoIP Perspectives XI
-
 Noticia
Noticia#NuevoSocioAseBio | “AseBio representa la fuerza nacional del sector biotecnológico siendo...
Conoce a nuestro nuevo socio Microviable Therapeutics. Entrevistamos a Claudio Hidalgo Cantabrana, CEO.
-
 Empresa
EmpresaNUAGE THERAPEUTICS
-
-
-
 Noticia
NoticiaBioDuro organiza el webinar: "Exploring Peptide In-Vitro ADME Properties – From Natural Pe...
Se explorarán las propiedades in-vitro de ADME (Absorción, Distribución, Metabolismo y Excreción) de los péptidos terapéuticos.
-
-
 Noticia
NoticiaEl ecosistema del Parque Científico de la Universidad de Barcelona mantiene el pulso inver...
Las 86 spinoffs, startups y scaleups que trabajan han conseguido captar 124,7 millones de euros, una cifra que supera la inversión del 2023, cerrada en 85,4 millones de euros.
-
 Noticia
NoticiaDía Mundial de la Esclerosis Múltiple | “La integración de biotecnología e IA nos permite ...
Entrevista con Mireia Forner, Medical Head Neurología en Sanofi Iberia, compañía que trabaja para cambiar la forma en que se entiende y se trata la esclerosis múltiple.
-
 Noticia
NoticiaLa Comisión Europea ha aprobado el Programa de Trabajo de Horizonte Europa 2025
La Comisión Europea ha aprobado el Programa de Trabajo Horizonte Europa para 2025 y destinará más de 7.300 millones de euros a investigación, innovación y competitividad
-
 Nota de prensa
Nota de prensaDía Mundial de la Esclerosis Múltiple | “La integración de biotecnología e IA nos permite ...
Entrevista con Mireia Forner, Medical Head Neurología en Sanofi Iberia, compañía que trabaja para cambiar la forma en que se entiende y se trata la esclerosis múltiple. Cada año se diagnostican en
-
 Convocatoria
ConvocatoriaConvocatoria INNVIERTE Deep-Tech Tech Transfer 2025




